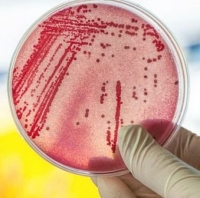

Pela primeira vez, cientistas encontraram uma alternativa aos antibióticos para o tratamento de superbactérias. O feito é um importante avanço no combate a esses microrganismos, que com o tempo se tornam resistentes a grande parte dos medicamentos disponíveis.
Segundo reportagem publicada no jornal britânico The Times nesta quinta-feira, um pequeno estudo feito com seres humanos mostrou que a nova droga é eficaz contra a MRSA (abreviação em inglês para Staphylococcus aureus resistente à meticilina), bactéria que não responde a vários tipos de antibióticos.
A pesquisa foi desenvolvida pela empresa de biotecnologia Clinical Microbiologist at Micreos, da Holanda. A droga contém um vírus que, por meio de uma enzima chamada endolisina, ataca bactérias. Em laboratório, os cientistas modificaram essa enzima, fazendo com que elas conseguissem destruir a parede das células da MRSA sem prejudicar microrganismos benéficos ao corpo.
Essa ação é diferente da dos antibióticos, que atacam o interior das células bacterianas. No entanto, certas bactérias, como a MRSA, evoluíram e passaram a ter membranas impermeáveis. Os pesquisadores acreditam que as superbactérias não devem desenvolver resistência à nova droga, pois é improvável que mutações genéticas impeçam a enzima de atacar as paredes celulares.
Um medicamento contendo a enzima endolisina já existe em forma de creme e é indicado para tratar infecções variadas de pele, como a acne. Agora, os pesquisadores esperam disponibilizar a substância na versão injetável ou oral dentro dos próximos cinco anos.
Resultados — O estudo holandês foi apresentado para a comunidade científica nesta quarta-feira, durante conferência sobre antibióticos em Londres. Segundo os cientistas, a droga, denominada Staphefekt, foi eficaz em destruir tanto as estirpes comuns quanto as resistente aos antibióticos da MRSA. Além disso, em um estudo observacional, o medicamento eliminou a bactéria do organismo de cinco entre seis pacientes com infecções de pele.
"Isso marca uma nova era na luta contra bactérias resistentes a antibióticos. Milhões de pessoas poderão ser beneficiadas. É algo muito animador e gratificante", disse, ao The Times, Mark Offerhaus, diretor executivo da Clinical Microbiologist at Micreos.
Superbactérias — Há poucos anos, as superbactérias estavam restritas a ambientes hospitalares, locais com circulação de pacientes com quadros agudos. Mas elas estão entrando nos ambientes cotidianos. Um estudo feito em conjunto pela Universidade da Califórnia (UCLA) e a Universidade Stony Brook, nos Estados Unidos, mostrou que, em muitas partes do mundo, a MRSA já é a causa mais comum de infecções de pele, e que esse aumento está relacionado à aparição da bactéria no dia a dia das comunidades.
"Todos nós estamos conscientes de que o apocalipse pós-antibiótico está próximo, e não será mais possível utilizar esses medicamentos por causa da resistência. Estamos desesperados por novas alternativas, e essa nova droga parece estar na vanguarda", disse, ao jornal britânico, Brenda Wren, especialista em doenças infecciosas da London School of Hygiene and Tropical Medicine.